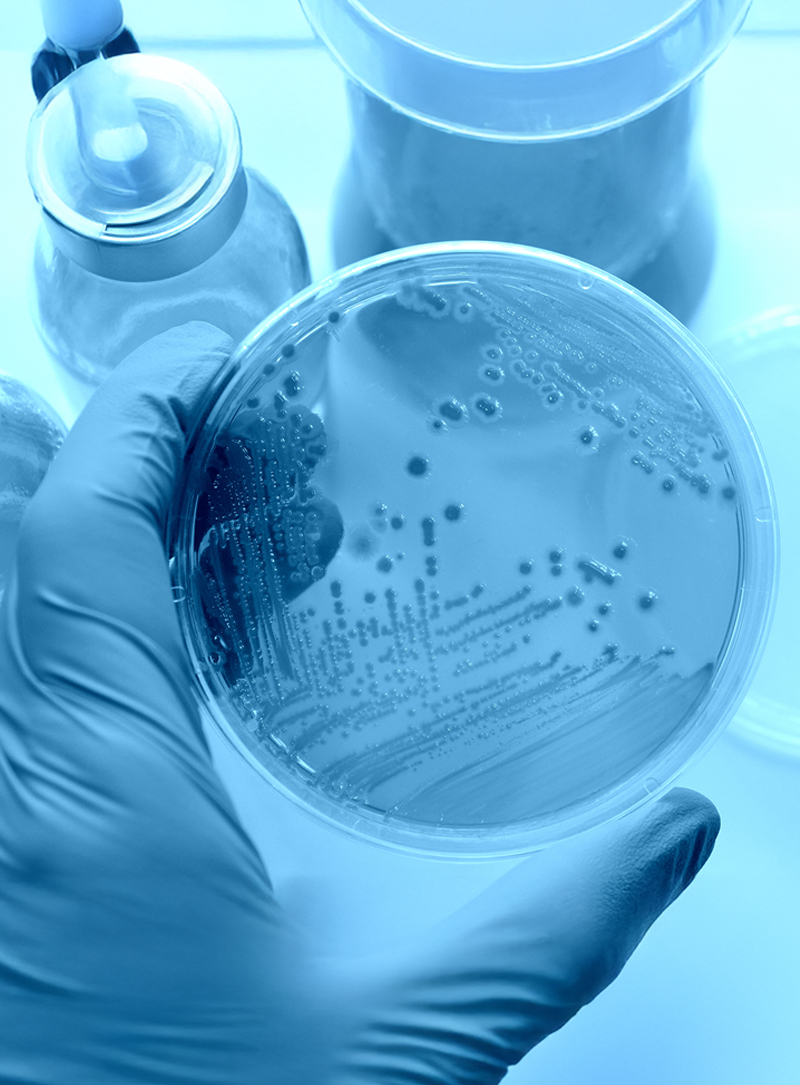

ASSOCIATION
専門医会のご案内
最新情報
一般社団法人日本臨床検査専門医会からのお知らせ、行事、セミナーのご案内など最新の情報をお届けします。
検査を通じて、医療の発展と人々の健康に貢献していくことが一般社団法人日本臨床検査専門医会の願いです。
理事長挨拶
「臨床検査専門医」は臨床検査室で何をするのですか?という問いかけに明確に答え、そして日常診療での活動のあり方をモデルケースとして提示したいと考えています。

歩みと活動
平成の時代に幕が降り、新しい時代が始まる2019年は、臨床検査にとっても改正医療法、改正臨検法、そして改正省令で示された検体検査の精度の確保への本格的な取組が求められることになります。

臨床検査専門医とは
検査室を管理するとともに、検査にかかわる診断業務を行う医師です。検査技師の方々と協力して、検査を適切に実施し、正確·精確なデータを返却できるよう、努力しています。
事業案内
私たち臨床検査専門医は、提出された検体が迅速にかつ精度良く処理されることを重要視しています。
また、得られた結果を正しく解釈するには、検査に関する専門知識が必要となります。
経験を積み、正確かつ効率的に業務を行えた際の喜びはとても大きなものです。
臨床検査に情熱を持ち、可能性を追求する方のご入会をお待ちしております。
臨床検査専門医の求人情報を掲載しております。